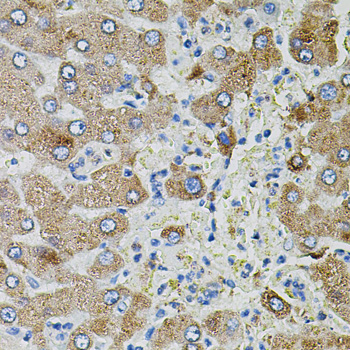
Валидация Elabscience E-AB-65923

| UNIPROT | P01135 |
| Иммуноген | Рекомбинантный гибридный белок из человеческого TGFA (NP_003227.1) |
TGFA Polyclonal Antibody (E-AB-65923)
Реактивность подтвержденная:
человек, мышь
Источник (хозяин):
кролик
Валидировано для:
IHC
Характеристики
Техническое описание
| Каталожный номер | E-AB-65923 |
| Название антигена | Transforming Growth Factor Alpha (TGFa) |
| UNIPROT | P01135 |
| Иммуноген | Рекомбинантный гибридный белок из человеческого TGFA (NP_003227.1) |
| Английские синонимы | ETGF, TGF-A, Protransforming Growth Factor alpha, EGF-Like TGF |
Реактивность подтвержденная Нужна другая реактивность? |
человек, мышь |
| Источник (хозяин) | кролик |
| Изотип | IgG |
| Клональность | поликлональное |
| Рекомбинантное | нет |
| Готовое к использованию | нет |
| Концентрация | 1мг/мл |
| Конъюгат | нет |
| Валидировано для | IHC Иммуногистохимия |
| Рекомендуемые разведения | IHC 1:50-1:100 |
| Метод очистки | Аффинная хроматография |
| Состав буфера | PBS с 0.02% азид натрия, 50% глицерин, pH7.3 |
| Условия доставки | термобокс с аккумуляторами холода |
| Условия хранения | Хранить при -20°C - 12 месяцев. Избегать повторяющихся циклов замораживания/оттаивания |
| Срок хранения | 12 месяцев |
| Производитель | Elabscience |
| Ссылка на страницу товара на сайте производителя | https://www.elabscience.com/p-tgfa_polyclonal_antibody-e_ab_65923 |
|
Артикул
|
Наименование |
Производитель
|
|---|
|
Артикул
|
Наименование |
Производитель
|
|---|
|
Артикул
|
Наименование |
Производитель
|
|---|
|
Артикул
|
Наименование |
Производитель
|
|---|
|
Артикул
|
Наименование |
Производитель
|
|---|
|
Артикул
|
Наименование |
Производитель
|
|---|
|
Артикул
|
Наименование |
Производитель
|
|---|
|
Артикул
|
Наименование |
Производитель
|
|---|
|
Артикул
|
Наименование |
Производитель
|
|---|
Акции и предложения
Популярные продукты:
LRP6 Polyclonal Antibody (E-AB-93103)
Источник (хозяин): кролик
Реактивность подтвержденная: человек, мышь, крыса
Валидировано для: WB
Реактивность подтвержденная: человек, мышь, крыса
Валидировано для: WB
AF/LE Purified Anti-Mouse CD19 Antibody[1D3] (E-AB-F09860)
Источник (хозяин): крыса
Реактивность подтвержденная: мышь
Валидировано для: FCM
Реактивность подтвержденная: мышь
Валидировано для: FCM
Instant ELISA Kit for Interleukin 8 (IL8) (IEA080Ov)
Организм: овца
Диапазон определения: 15.6-1000 пг/мл
Чувствительность: 6.3 пг/мл
Диапазон определения: 15.6-1000 пг/мл
Чувствительность: 6.3 пг/мл
Anti-Indoxyl Sulfate/IS Antibody (SAb2281) (RGP15402)
Источник (хозяин): мышь
Реактивность подтвержденная: для всех
Валидировано для: ELISA
Реактивность подтвержденная: для всех
Валидировано для: ELISA
Anti-HRV-14 Capsid protein VP3 Antibody (SAA2230) (RVV07703)
Источник (хозяин): человек
Реактивность подтвержденная: вирусы
Валидировано для: ELISA
Реактивность подтвержденная: вирусы
Валидировано для: ELISA